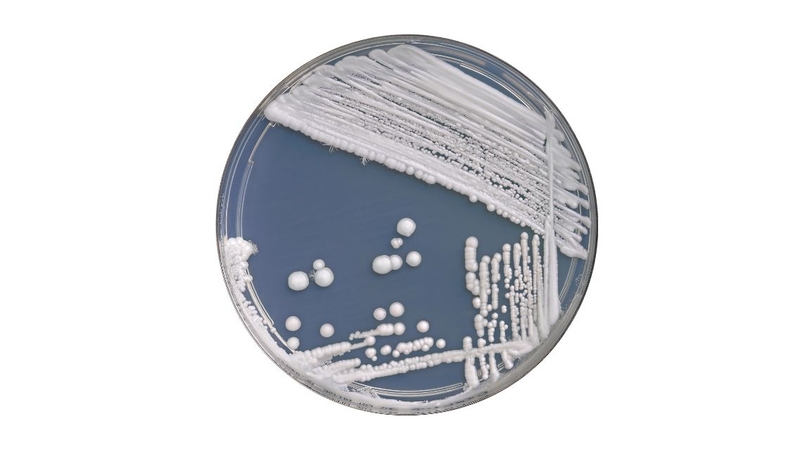
Xét nghiệm nấm Candida: Gồm những gì và khi nào cần thực hiện 2

Tốt nghiệp Đại học Y Dược TP. Hồ Chí Minh. Có nhiều năm trong lĩnh vực dược phẩm. Hiện đang là giảng viên cho Dược sĩ tại Nhà thuốc Long Châu.
Thanh Hương
18/09/2025
Mặc định
Lớn hơn
Nấm Candida là tác nhân gây nên nhiều bệnh lý khó chịu, đặc biệt ở da, niêm mạc và cơ quan sinh dục. Để xác định chính xác tình trạng nhiễm nấm, xét nghiệm Candida là bước cần thiết giúp chẩn đoán và đưa ra hướng điều trị kịp thời. Vậy xét nghiệm nấm Candida gồm những gì và khi nào nên thực hiện?
Nhiễm nấm Candida là tình trạng khá phổ biến nhưng dễ bị nhầm lẫn với các bệnh lý khác nếu không được kiểm tra đúng cách. Xét nghiệm nấm Candida giúp phát hiện sớm tác nhân gây bệnh và hỗ trợ bác sĩ xây dựng phác đồ điều trị phù hợp. Bạn hãy cùng Nhà thuốc Long Châu tìm hiểu xét nghiệm này bao gồm những gì và khi nào cần thực hiện qua bài viết dưới đây!
Nấm Candida là một loại nấm men tồn tại tự nhiên trong cơ thể người, chủ yếu ở miệng, họng, đường ruột, da và vùng sinh dục.
Trong điều kiện bình thường, nấm Candida không gây hại vì hệ miễn dịch và hệ vi sinh vật trong cơ thể kiểm soát tốt sự phát triển của chúng. Tuy nhiên, khi môi trường cân bằng bị phá vỡ, nấm Candida có thể phát triển quá mức và gây bệnh.
Loại phổ biến nhất là Candida albicans, gây ra các bệnh lý như nấm miệng, nấm vùng kín, nhiễm nấm ngoài da hoặc nhiễm trùng toàn thân ở những người có hệ miễn dịch yếu.
Để xác định chính xác tình trạng nhiễm nấm Candida, xét nghiệm là bước cần thiết và quan trọng.
Mục đích của xét nghiệm nấm Candida là giúp bác sĩ kiểm tra rõ ràng bạn có đang bị nhiễm loại nấm này hay không, từ đó tránh nhầm lẫn với các tác nhân gây viêm nhiễm khác như vi khuẩn, ký sinh trùng hoặc virus.
Việc chẩn đoán chính xác không chỉ giúp điều trị hiệu quả, mà còn hạn chế nguy cơ tái phát hoặc nhờn thuốc do điều trị sai cách.

Việc xét nghiệm nấm Candida nên được thực hiện khi có các triệu chứng nghi ngờ nhiễm nấm tại bất kỳ vị trí nào như miệng, da, vùng kín, hoặc khi nghi ngờ nhiễm Candida toàn thân, đặc biệt ở những người có yếu tố nguy cơ như suy giảm miễn dịch.
Điển hình nhất là tình trạng ngứa vùng kín, khí hư ra nhiều, có màu trắng đục hoặc vón cục như bã đậu, đôi khi kèm mùi hôi nhẹ hoặc không mùi. Khi có cảm giác nóng rát khi quan hệ tình dục hoặc khi đi tiểu, vùng âm đạo - âm hộ có thể bị sưng tấy, đỏ rát cũng là lúc bạn nên thực hiện xét nghiệm nhiễm nấm.
Ngoài ra, xét nghiệm nấm Candida cũng được khuyến nghị trong các trường hợp:
Để phát hiện chính xác tình trạng nhiễm nấm Candida, các bác sĩ sẽ chỉ định thực hiện một hoặc kết hợp nhiều phương pháp xét nghiệm khác nhau, tùy vào tình trạng cụ thể của từng người. Dưới đây là những phương pháp xét nghiệm phổ biến nhất hiện nay:
Soi tươi dịch âm đạo là bước kiểm tra cơ bản và nhanh chóng nhất. Bác sĩ sẽ lấy mẫu dịch âm đạo và quan sát trực tiếp dưới kính hiển vi để tìm kiếm sự hiện diện của nấm Candida.
Phương pháp này giúp phát hiện nhanh tác nhân gây viêm, nhưng có thể bỏ sót trong trường hợp số lượng nấm ít hoặc giai đoạn đầu của bệnh.
Nhuộm Gram là kỹ thuật giúp đánh giá chính xác hơn tình trạng viêm nhiễm tại âm đạo. Qua việc nhuộm mẫu bệnh phẩm, bác sĩ có thể quan sát rõ cấu trúc tế bào nấm Candida và nhận diện sự hiện diện của chúng.
Đồng thời, nhuộm Gram cũng giúp phát hiện các loại vi khuẩn khác gây viêm nhiễm phối hợp.
Đối với những trường hợp nhiễm nấm tái phát nhiều lần hoặc nghi ngờ có sự hiện diện của các chủng nấm kháng thuốc, bác sĩ sẽ chỉ định thực hiện nuôi cấy dịch âm đạo để xét nghiệm nấm candida.
Phương pháp này giúp xác định chính xác chủng loại nấm Candida đang gây bệnh, từ đó lựa chọn phác đồ điều trị phù hợp, hạn chế nguy cơ tái phát hoặc nhờn thuốc.
Xét nghiệm máu có thể phát hiện sự hiện diện của nấm Candida, đặc biệt trong trường hợp nghi ngờ nhiễm nấm Candida xâm lấn hoặc nhiễm trùng toàn thân. Tuy nhiên, với các trường hợp nhiễm nấm nhẹ ở da, niêm mạc hay vùng kín, xét nghiệm máu thường không cần thiết.

Xét nghiệm PCR (Polymerase Chain Reaction) là phương pháp sinh học phân tử hiện đại giúp phát hiện DNA của nấm Candida trong mẫu bệnh phẩm (dịch âm đạo, máu, nước tiểu,...).
Xét nghiệm PCR giúp phát hiện DNA của nấm Candida với độ nhạy cao, kể cả khi số lượng nấm thấp hoặc chưa nuôi cấy thành công. Tuy nhiên, xét nghiệm này không phân biệt được giữa hiện diện đơn thuần và nhiễm trùng thực sự, nên cần kết hợp với đánh giá lâm sàng để đưa ra chẩn đoán chính xác.
Hiện nay, một số bộ kit xét nghiệm tại nhà hỗ trợ lấy mẫu dịch âm đạo để kiểm tra nấm Candida, tuy nhiên các kit này chủ yếu mang tính chất sàng lọc, chưa được cơ quan y tế lớn như FDA chính thức công nhận về độ chính xác. Để đảm bảo kết quả tin cậy và điều trị đúng cách, nên thực hiện xét nghiệm tại cơ sở y tế uy tín.
Kết quả xét nghiệm nấm Candida dương tính nghĩa là trong mẫu bệnh phẩm (dịch âm đạo, dịch họng, máu, nước tiểu,...) đã phát hiện sự hiện diện của nấm Candida. Điều này cho thấy bạn đang bị nhiễm nấm Candida tại vị trí lấy mẫu.
Kết quả âm tính có nghĩa là không phát hiện sự hiện diện của nấm Candida trong mẫu xét nghiệm. Khi đó, các triệu chứng (nếu có) không liên quan đến nhiễm nấm Candida, mà có thể do nguyên nhân khác như viêm do vi khuẩn, virus hoặc tác nhân khác.
Nhiễm nấm Candida ở da, miệng, âm đạo là tình trạng phổ biến, thường không nguy hiểm nếu được điều trị đúng cách, kịp thời. Tuy nhiên, ở người suy giảm miễn dịch hoặc khi không được điều trị thích hợp, tình trạng này có thể tiến triển nặng hoặc tái phát nhiều lần.

Nhiễm nấm Candida ở đường tiết niệu hoặc máu là trường hợp nghiêm trọng, đặc biệt ở người suy giảm miễn dịch, người bệnh nền, trẻ sơ sinh hoặc bệnh nhân nằm viện lâu ngày. Khi đó, nấm có thể xâm nhập vào máu, gây nhiễm trùng huyết, ảnh hưởng đến tính mạng nếu không được điều trị kịp thời.
Nấm Candida là nguyên nhân gây viêm nhiễm phụ khoa phổ biến nhưng hoàn toàn có thể kiểm soát nếu được phát hiện và điều trị đúng cách.
Xét nghiệm nấm Candida là bước cần thiết giúp chẩn đoán chính xác tình trạng viêm nhiễm, tránh tự ý dùng thuốc gây nhờn thuốc hoặc tái phát kéo dài. Khi có khí hư bất thường hay ngứa vùng kín, bạn nên chủ động thăm khám tại các cơ sở y tế uy tín để được tư vấn thực hiện xét nghiệm phù hợp và điều trị triệt để.
Dược sĩ Đại họcNguyễn Vũ Kiều Ngân
Tốt nghiệp Đại học Y Dược TP. Hồ Chí Minh. Có nhiều năm trong lĩnh vực dược phẩm. Hiện đang là giảng viên cho Dược sĩ tại Nhà thuốc Long Châu.